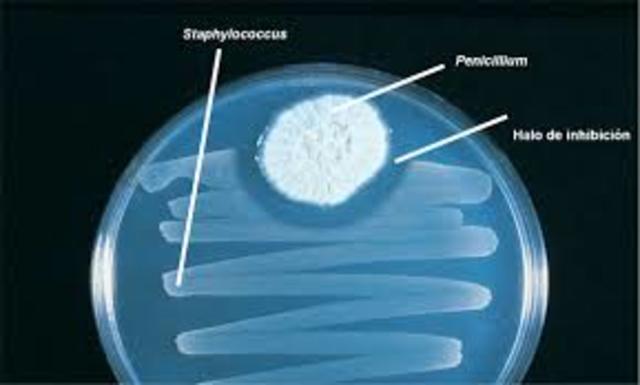
Descubrimiento de la pinicilina

-
El microscopio fue inventado por Zacharias Janssen en 1590. En 1665 aparece en la obra de William Harvey sobre la circulación sanguínea al mirar al microscopio los capilares sanguíneos, y Robert Hooke publicó su obra Micrographia, además fue quien observó con un microscopio un delgado corte de corcho y notó que el material era poroso, en su conjunto, formaban cavidades poco profundas a modo de celditas a las que llamó células.
-
En la máquina de vapor se basa la Primera Revolución Industrial que, desde fines del siglo XVIII en Inglaterra y hasta casi mediados del siglo XIX, aceleró portentosamente el desarrollo económico de muchos de los principales países de la Europa Occidental y de los Estados Unidos. Solo en la interfase que medió entre 1890 y 1930 la máquina a vapor impulsada por hulla dejó lugar a otros motores de combustión interna: aquellos impulsados por hidrocarburos derivados del petróleo.
-
El científico y diplomático ruso Pavel Schilling, a partir de sus conocimientos creó en 1832 otro telégrafo electromagnético, cuyo emisor era un tablero de 16 teclas en blanco y negro, como las de un piano, que servía para enviar los caracteres, mientras que el receptor consistía de seis galvanómetros de agujas suspendidas por hilos de seda cuyas de flexiones servían de indicación visual de los caracteres enviados.
-
Los orígenes de los motores son muy remotos. Especialmente si se consideran los inicios o precedentes de algunos elementos constitutivos de los motores, imprescindibles para su funcionamiento como tales. Considerados como máquinas completas y funcionales, y productoras de energía mecánica, hay algunos ejemplos de motores antes del siglo XIX. A partir de la producción comercial de petróleo a mediados del siglo XIX (1850) las mejoras e innovaciones fueron muy importantes. A finales de ese siglo h
-
Durante siglos se dieron tímidos intentos por alzar el vuelo, fracasando la mayor parte de ellos, pero ya desde el siglo XVIII el ser humano comenzó a experimentar con globos aerostáticos que lograban elevarse en el aire, pero tenían el inconveniente de no poder ser controlados. Ese problema se superó ya en el siglo XIX con la construcción de los primeros dirigibles, que sí permitían su control. El 17 de diciembre de 1903 los hermanos Wright se convirtieron en los primeros en realizar un vuelo.
-
Si bien el período entre principios de siglo y la Segunda Guerra Mundial (1900 a 1940) ha sido considerado la edad de oro de la genética, los científicos aún no habían determinado que, en el ADN y no en las proteínas, se encontraba el material hereditario. Sin embargo en esa época se realizaron muchos descubrimientos genéticos y se estableció la relación entre genética y evolución.
-
La penicilina G o bencipenicilina fue el primer antibiótico empleado ampliamente en medicina; su descubrimiento ha sido atribuido a Alexander Fleming en 1928.
-
La energía nuclear es la energía que se obtiene al manipular la estructura interna de los átomos. Se puede obtener mediante la división del núcleo (fisión nuclear) o la unión de dos átomos (fusión nuclear).
-
Apolo 11 fue una misión espacial tripulada de Estados Unidos cuyo objetivo fue lograr que un ser humano caminara en la superficie de la Luna. La misión se envió al espacio el 16 de julio de 1969, llegó a la superficie de la Luna el 20 de julio de ese mismo año y al día siguiente logró que 2 astronautas (Armstrong y Aldrin) caminaran sobre la superficie lunar.
-
La primera computadora portátil considerada como tal fue la Epson HX-20 desarrollada en 1981, a partir de la cual se observaron los grandes beneficios para el trabajo de científicos, militares, empresarios, y otros profesionales, que vieron la ventaja de poder llevar con ellos su computadora con toda la información que necesitaban de un lugar a otro.
-
El teléfono celular, o teléfono móvil, es un aparato indispensable en la actualidad; sin embargo su popularización ha sido un fenómeno muy reciente. En un principio el teléfono móvil solo podía ser usado en vehículos por su tamaño, reduciéndose posteriormente a una unidad portátil, y finalmente al tamaño de bolsillo que utilizamos hoy
-
Las unidades flash USB ( Universal Serial Bus) o pendrive, fueron inventadas en 1995 por IBM como un remplazo de las unidades de disquete.
las primeras unidades flash venían en tamaños de 8 MB, 16 MB, 32 MB y 64 MB -
Dolly fue en realidad una oveja resultado de una combinación nuclear desde una célula donante diferenciada a un óvulo no fecundado y anucleado (sin núcleo). La célula de la que venía Dolly era una ya diferenciada o especializada, procedente de un tejido concreto, la glándula mamaria, de un animal adulto (una oveja Fin Dorset de seis años), lo cual suponía una novedad. Hasta ese momento se creía que sólo se podían obtener clones de una célula embrionaria, es decir, no especializada.
Want to make a timeline like this?
Use Timetoast to turn dates, events, milestones, and phases into a clear visual timeline you can build and share. Timetoast is a timeline maker for work, school, research, and stories.